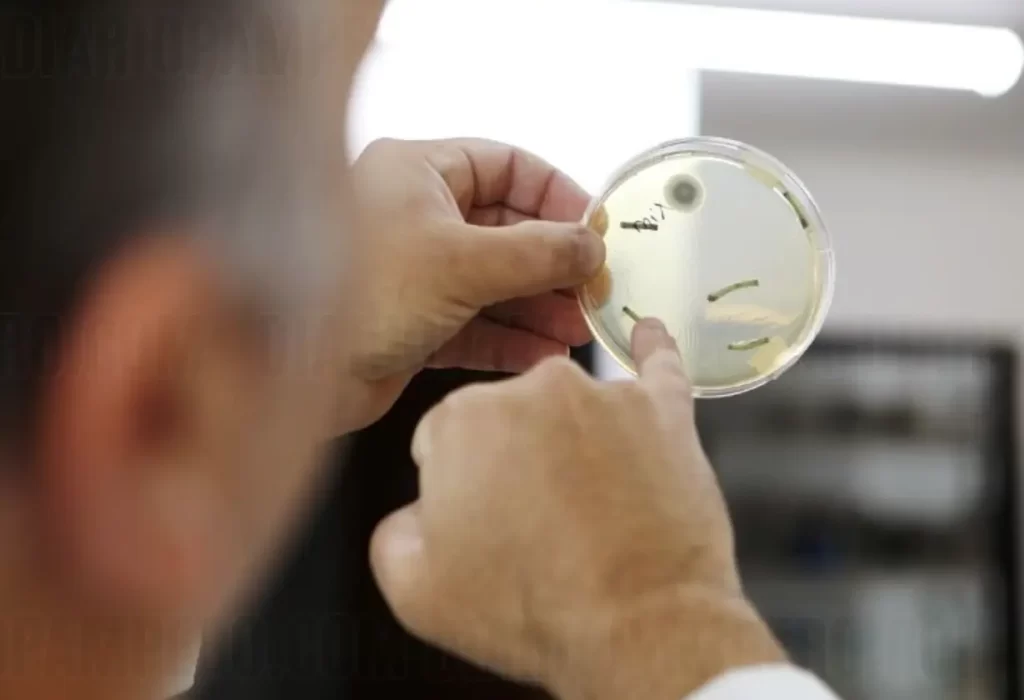

Científicos de la UNLP desarrollan un bioinsecticida a base de hongos para mejorar cultivos
Científicos de la Universidad Nacional de La Plata (UNLP) desarrollaron un bioinsecticida a base de hongos entomopatógenos nativos que mejora el rendimiento de los cultivos, informó la casa de estudios.
Los estudios se realizan en el Instituto Spegazzini, dependiente de la Facultad de Ciencias Naturales y Museo de la UNLP. El grupo trabaja con hongos patógenos de insectos, con el objetivo de modificar las prácticas de la agricultura tradicional por otras más amigables con el ambiente.
El director del Spegazzini, Sebastián Pelizza, explicó que «actualmente trabajamos en un bioinsecticida en base a hongos entomopatógenos nativos, que tienen la capacidad de actuar de manera endofítica«. Esto significa que pueden ingresar y permanecer en el interior de los cultivos una vez aplicados.
Este bioinsecticida se puede aplicar con las mismas herramientas que los insecticidas químicos convencionales. «La tecnología fue validada en ensayos de laboratorio y a campo sobre soja y maíz. Allí observamos que la acción de estos hongos endófitos mejora considerablemente la sanidad vegetal de los cultivos, ya que produce un efecto de repelencia sobre los insectos plagas«, afirmó Pelizza.
Además, en los ensayos realizados se comprobó un mayor rendimiento en kg/ha. Esto se debe a que los microorganismos ayudan a incorporar más nutrientes del suelo y sintetizan fitohormonas que benefician el desarrollo de las plantas.
Los resultados promisorios permitieron que el grupo fuera seleccionado entre más de 80 proyectos para recibir financiamiento privado a través de la compañía SF500.
«Es importante mencionar que la UNLP, a través de la incubadora de ideas Minerva, fue la que nos motivó para que este proyecto salga del ámbito académico y fuera en busca de inversiones privadas para el desarrollo de una empresa de base tecnológica«, remarcó Pelizza.
En síntesis, el bioinsecticida desarrollado por científicos platenses basado en hongos nativos es una alternativa sustentable a los agroquímicos que mejora los cultivos y cuenta con el respaldo de inversionistas privados para su producción industrial.
DESCARGAR APLICACIÓN DE LA RADIO EN VIVO
Gracias por estar en Diario Pampero, visítanos para estar informado!
Si necesitas parte de este contenido, no olvides citar la fuente de información. Respetamos a quienes producen contenidos, artículos, fotos, videos. Compartimos información de La Pampa para los pampeanos y te informamos sobre toda la actualidad nacional e internacional destacada.
Si compartes nuestro contenido, nos ayudas a crecer como medio de comunicación!







